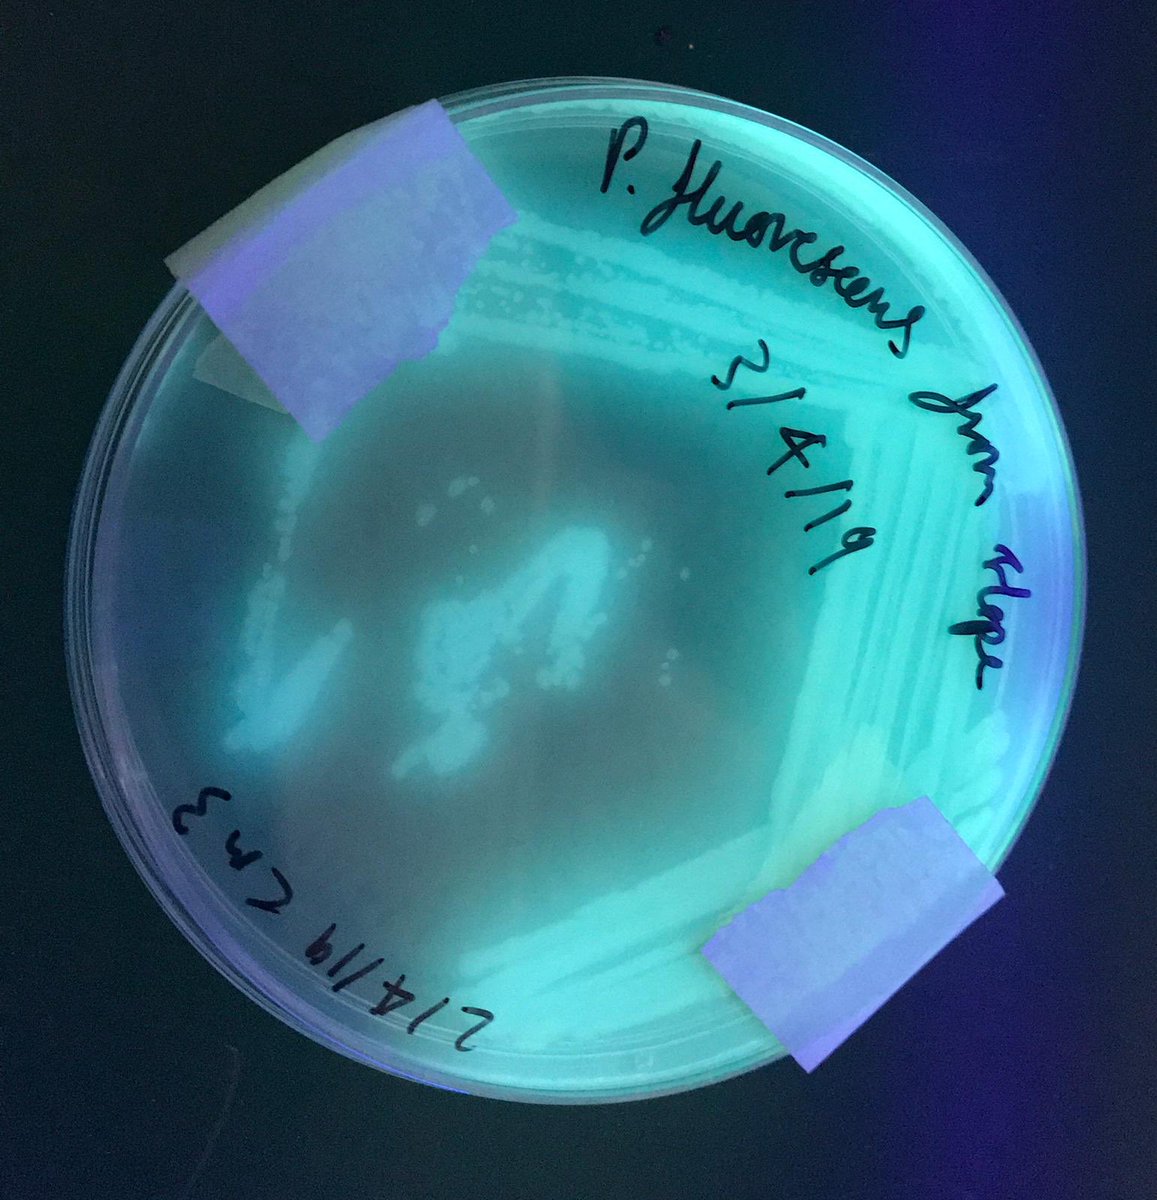
Microbiology just got more exciting <a href="/CastleviewUl/">CastleviewUL</a> with <a href="/2ndry_microbiol/">Ben McDonagh</a> in the team #TeamScience #EducationWithCharacater

Laura Watford
@cvsciencedept
Head of Science at Castle View Academy, Portsmouth
ID: 1043502320879919106
22-09-2018 14:08:35
34 Tweet
46 Followers
80 Following


The fantastic Institute of Physics roadshow 'Ever Wondered Why?' is coming to CVA on Wednesday 27th March. This will be offered to the year 5 students from all our local feeder schools Beacon View Primary Victory Primary as either a morning or afternoon session.

Great to have the expertise of Ben McDonagh in Team Science CastleviewUL #educationwithcharacter

Getting ready for the @IOPLSE show with Trevor Plant and most of the year 5s from the North of Portsmouth Beacon View Primary Victory Primary #MedinaSchool


Flames and stars @IOPLSE #IOPShow with Trevor Plant ✨ and year 5 from Beacon View Primary Victory Primary CastleviewUL #ExcitingScience


A Firenado from Trevor @IOPLSE #StimulatingPhysicsNetwork Roadshow CastleviewUL #EducationwithCharacter Victory Primary Victory Primary


Whoosh and a round of applause for Trevor from the @IOPLSE #StimulatingPhysicsNetwork CastleviewUL Victory Primary Beacon View Primary #MedinaSchool #RocketScience

The afternoon session welcomes St Paul’s, Portsdown and West Hill Park school. Ready to see some #rocketscience with Trevor Plant @IOPLSE CastleviewUL


Great summary science videos for revision this Easter for our Year 10 & 11 students CastleviewUL

Microbiology just got more exciting CastleviewUL with Ben McDonagh in the team #TeamScience #EducationWithCharacater

Great resources as the exams are getting closer. CastleviewUL #year11 #AQAScience

Wishing our CastleviewUL team at @S4TP_BigIdeas regional finals the best luck today. I’m looking forward to take last years finalists to RAEngEducation to present their experience. #STEM #Educationwithcharacter


Looking forward to welcoming a group of students to Victory Primary students to investigate volcanoes 🌋 today CastleviewUL

Kane and Oakley have been experimenting with the death worm, they can explain the science behind it beautifully ✨ CastleviewUL #EducationWithCharacter



To celebrate 50 years since Apollo 11 launch, the science dept CastleviewUL had all kinds of lovely experiments related to space.


Laura Watford CastleviewUL Fantastic! We always love to hear about how the resources are being used. And for those that have not received physical copies, all resources can be downloaded for free on our website - stemresources.raeng.org.uk

Laura Watford CastleviewUL Amazing! Look at them go! Hope the open evening went well 🙌.


